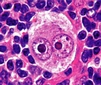
Non Hodgkin Lenfoma Belirtileri ve Tedavisi

Lenfoma Hodgkin Belirtileri ve Tedavisi
Lenfoma Hodgkin, lenfatik sistemi etkileyen bir kanser türüdür ve erken tanı ile tedavi edilmesi durumunda yüksek iyileşme oranlarına sahiptir. Bu yazıda, hastalığın belirtileri, tanı yöntemleri ve tedavi seçenekleri hakkında detaylı bilgi sunulmaktadır. Erken tespit ve düzenli sağlık kontrollerinin önemi vurgulanmaktadır.
Lenfoma Hodgkin, lenfatik sistemin kanserlerinden biri olup, özellikle genç yetişkinler ve orta yaş grubundaki bireylerde daha yaygın olarak görülmektedir. Bu hastalık, lenf düğümlerinin anormal büyümesi ile karakterizedir ve tedavi edilmediğinde hayati tehlike oluşturabilir. Bu makalede Lenfoma Hodgkin'in belirtileri, tanı yöntemleri ve tedavi seçenekleri detaylı bir şekilde incelenecektir. Lenfoma Hodgkin Nedir?Lenfoma Hodgkin, B hücreli lenfositlerin malign transformasyonu sonucu oluşan bir lenfoma türüdür. Hodgkin lenfomasının en belirgin özelliği, Reed-Sternberg hücrelerinin varlığıdır. Bu hücreler, lenfoma tanısı konulmasında temel bir role sahiptir. Hodgkin lenfoması, genel olarak iki ana tipe ayrılır: klasik Hodgkin lenfoması ve nodüler sklerozan Hodgkin lenfoması. Lenfoma Hodgkin BelirtileriLenfoma Hodgkin'in belirtileri genellikle yavaş bir şekilde gelişir ve aşağıdaki gibi sıralanabilir:
Lenfoma Hodgkin TanısıTanı, genellikle aşağıdaki yöntemlerle konulmaktadır:
Lenfoma Hodgkin TedavisiTedavi seçenekleri, hastalığın evresine ve hastanın genel sağlık durumuna bağlı olarak değişiklik göstermektedir. Genel olarak tedavi yöntemleri şunlardır:
Lenfoma Hodgkin İle İlgili Ekstra BilgilerLenfoma Hodgkin, erken evrelerde tedavi edildiğinde yüksek iyileşme oranlarına sahip bir hastalıktır. Bununla birlikte, hastalığın seyrine göre bazı risk faktörleri bulunmaktadır:
Sonuç olarak, Lenfoma Hodgkin, erken tanı ve uygun tedavi yöntemleri ile yönetilebilen bir hastalıktır. Belirtilerinin farkında olmak ve düzenli sağlık kontrolleri yaptırmak, hastalığın erken teşhisi için kritik öneme sahiptir. Tıbbi müdahale gerektiren bu durumda, uzman bir hekime başvurmak en doğru adım olacaktır. |

Lenfoma Hodgkin tanısı alan bir hastayım ve doktorum bana Reed-Sternberg hücrelerinin bu hastalığın karakteristiği olduğunu söyledi. Bu hücrelerin varlığı hastalığın kesin tanısı için yeterli midir? Ayrıca, Waldeyer halkası ve mezenterik nodların nadiren tutulduğunu belirtti; bu durum benim için ne anlama geliyor? Tedavi sürecimde kemoterapi ve radyoterapinin birlikte uygulanabileceğinden bahsedildi, bu tedavi yöntemlerinin yan etkileri nelerdir?
Reed-Sternberg Hücreleri
Reed-Sternberg hücreleri, Hodgkin lenfoma tanısının belirleyici özelliğidir. Bu hücrelerin varlığı, hastalığın kesin tanısını destekleyen önemli bir bulgudur. Ancak, tanı koyabilmek için sadece bu hücrelerin varlığı yeterli olmayabilir; hastalığın evrelemesi ve diğer klinik bulgular da dikkate alınmalıdır.
Waldeyer Halkası ve Mezenterik Nodlar
Waldeyer halkası ve mezenterik nodların nadiren tutulması, hastalığın daha sınırlı bir formda olduğunu veya belirli bölgelerde daha az yayılım gösterdiğini gösterebilir. Bu durum, tedavi sürecinizin seyrini ve prognozunu etkileyebilir. Genellikle, lenfoma hastalarının tedavi sonuçları, hastalığın yayılım derecesine bağlı olarak değişiklik göstermektedir.
Tedavi Yöntemleri ve Yan Etkileri
Kemoterapi ve radyoterapi, Hodgkin lenfoma tedavisinde yaygın olarak kullanılan yöntemlerdir. Kemoterapi sırasında bulantı, kusma, yorgunluk, saç dökülmesi ve bağışıklık sistemi zayıflığı gibi yan etkiler görülebilir. Radyoterapi ise ciltte tahriş, yorgunluk ve belirli bölgelerde hassasiyet gibi etkiler yapabilir. Her iki tedavi yöntemi de kişiden kişiye farklı yan etkiler gösterebilir, bu nedenle tedavi süreciniz boyunca doktorunuzla düzenli olarak iletişimde kalmanız önemlidir.